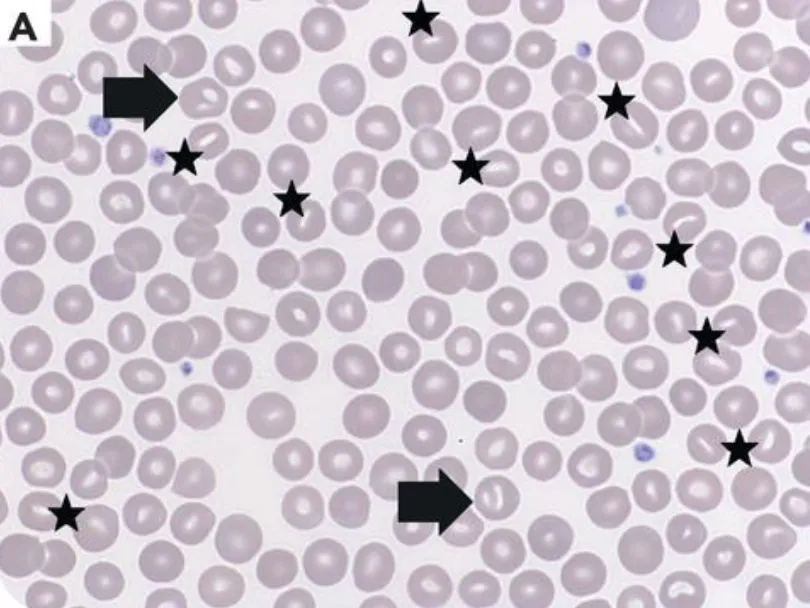
xerocytosis

Hereditary xerocytosis (HX) is an autosomal dominant disorder causing variable degrees of anemia and abnormal erythrocyte morphologies. The above smear has several interesting findings characteristic of HX, including stomatocytes (coffee-bean shaped cells) and knizocytes (RBCs with more than one pale central area) [1]. This disorder can be caused by variants in PIEZO1, KCNN4, RHAG, SLC4A1, and ABCB6.
What potential consequences require surveillance?
- As variable degrees of hemolysis may occur, occasional surveillance of complete blood counts and hemolysis markers is recommended. As in spherocytosis and other forms of hemolytic anemias, hemolysis may be exacerbated by various stressors.
- Neonates with HX may have increased risk of hydrops fetalis or severe polyhydramnios. It is our practice to pursue maternal fetal medicine consultation for heightened surveillance during pregnancy bearing a fetus with HX.
- Occasional surveillance of iron studies is recommended as patients are at risk of iron overload. If ferritin is elevated, MRI of liver should be pursued for iron quantitation.
- Recommend maintenance folate given higher blood turnover.
- Occasional transfusions may be needed in times of higher blood turnover.
- Splenectomy should be avoided if at all possible given increased risk of post-splenectomy complications including higher rates of thrombosis.
Literature
- Cordeil S, Jallades L. Polycythemia revealing PIEZO1 hereditary xerocytosis. Blood. 2024 Jul 4;144(1):123. doi: 10.1182/blood.2024024199. PMID: 38963666.
- Immacolata Andolfo, Achille Iolascon, Roberta Russo; The evolving landscape of hereditary stomatocytosis. Blood 2025; 145 (26): 3089–3100. doi: https://doi.org/10.1182/blood.2024024294
Last updated 2/1/2026